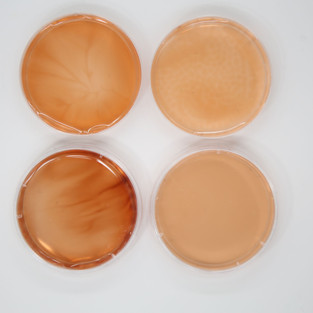

Totems | The Museum of Modern Art (MoMA), NYC
- Sara Laura Wilson
- Jun 8, 2020
- 1 min read
Mediated Matter Group at MIT Media Lab
Position: Undergraduate Researcher (UROP)
June 2019 — February 2020
Exhibition: Neri Oxman: Material Ecology
Melanin’s properties—such as broadband absorbance, electrical conductivity, and photoconductivity—lend itself to interesting potential applications in biomedicine and biotechnology. Developing a synthetic protocol with tunable design handles for Melanin will facilitate its incorporation in devices. This project seeks to address and speculate upon designers’ ability to chemically synthesize the “pigment of life” and program its interaction across scales and species. The technical goal is to understand, explain, and predict how Melanin can, along with other derivative pigments, be generated on demand. Other research interests include the environmental and human factors involved in its creation and how its formation can be tuned or even reversed to sustain and perpetuate diversity on our planet.

Photo courtesy of the Mediated Matter Group.

Totems in the MoMA. Photo by Denis Doorly.
The biosynthesis of Melanin from the natural world was translated into a set of chemical design protocols. Melanin substance was created in two ways. In one (shown above), a reaction between an active chemical, the enzyme tyrosinase, which was extracted from the Agaricus bisporus mushroom, converts a protein building block, the amino acid tyrosine, into melanin and its precursors. These pigments can be deployed in liquid or powder form to create unique, environmentally sensitive inks. In the second method, melanin can be extracted from a variety of natural sources, including cuttlefish ink and hair.
Photos by Sara L. Wilson.
Photos by Sara L. Wilson.
Direct supervisor: Sunanda Sharma
PI: Neri Oxman

Comments